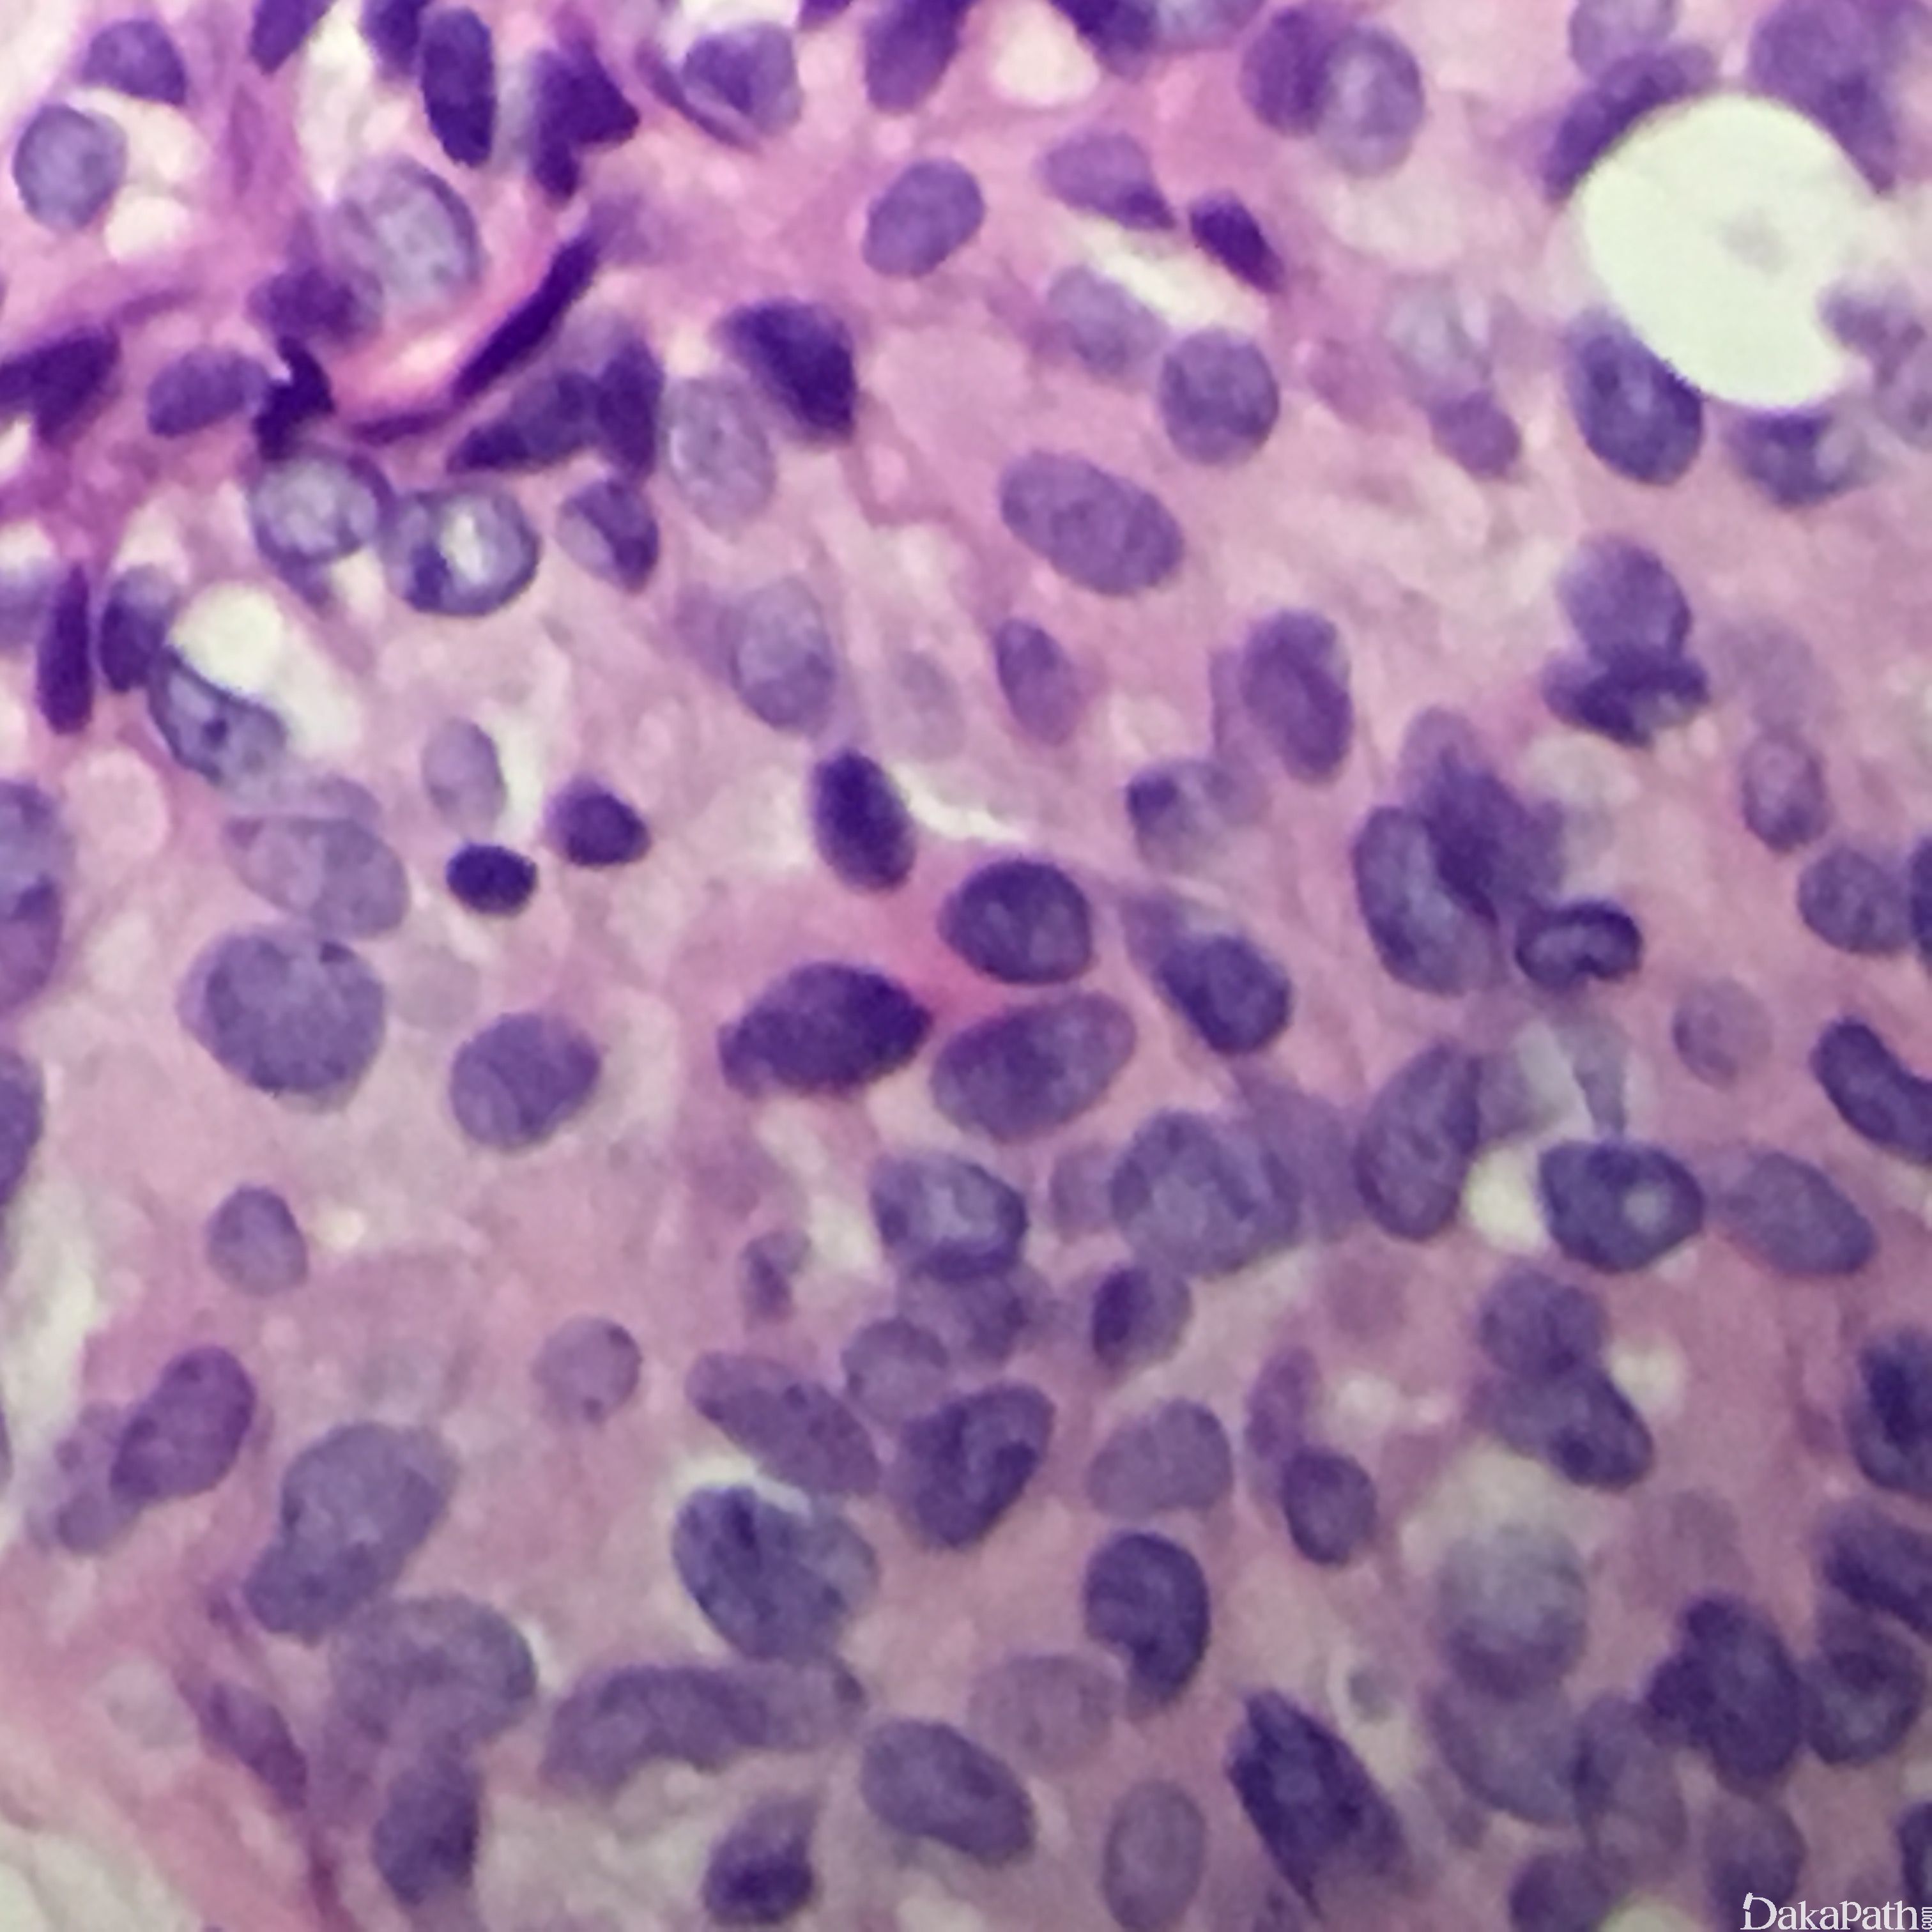
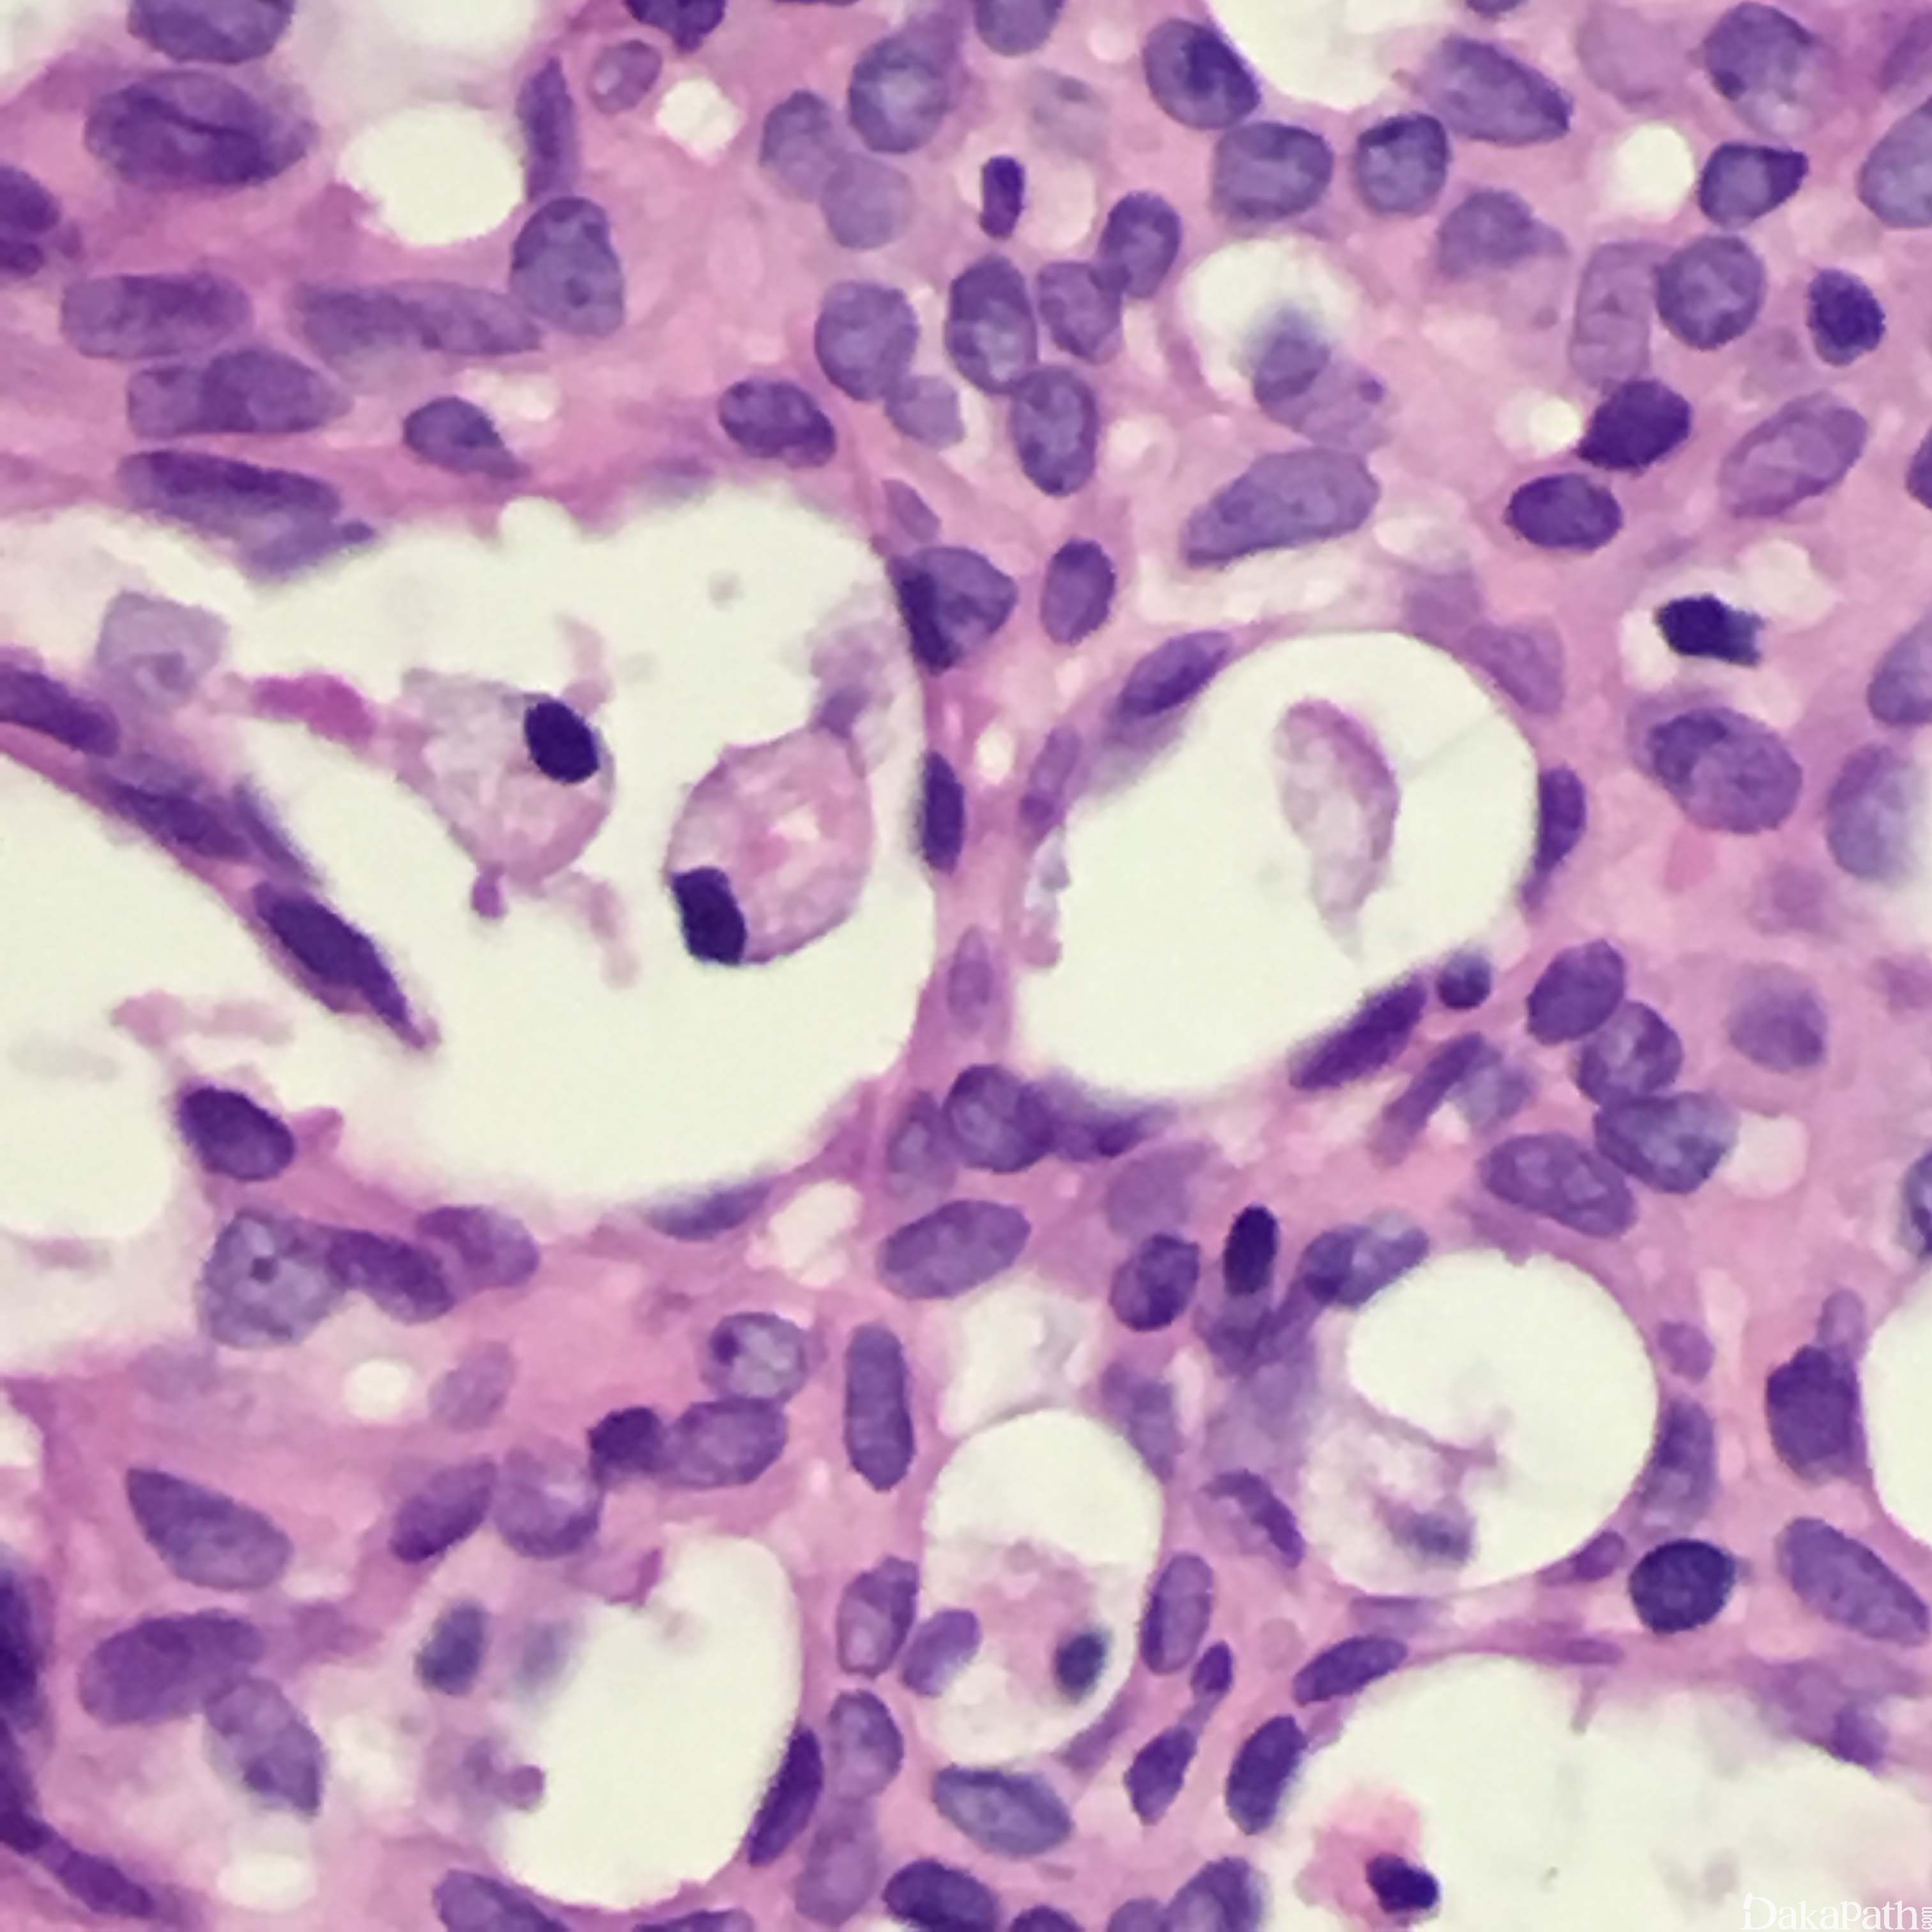

乳腺普通型导管增生
Breast Usual Ductal Hyperplasia,UDH
同义词(或曾用名): 导管内增生、普通型增生、上皮增殖、普通型导管内增生、没有非典型性的增生
概述:
这种病变以上皮实性或多孔增生为特征,细胞流水样排列,特别是在孔的中心部位。UDH 是一种良性的多克隆上皮增生,大多数情况下认为其并非癌前病变。
发病部位: 乳腺
诊断要点:
- UDH 多发生在 35-60 岁的女性,平均年龄 53 岁,60 岁以上的病人少见。UDH 是显微镜下的诊断,没有临床可触及的肿块及其他症状,也没有肉眼可见的表现,除了极少数伴有微小钙化的病例,乳腺 X 线照相一般看不到任何异常,人们往往是因为其他疾病就诊取活检发现 UDH,因此其发病率不详。25%的良性乳腺活检中可发现 UDH,旺炽性 UDH 在同侧或对侧乳腺发展浸润性癌的风险性增加 1.5-2.0 倍。UDH 常常与其他的良性病变,如硬化性腺病、大汗腺化生、间质增生等混合存在。
- 组织学结构特征:超过正常的乳腺的两层结构(肌上皮细胞和腺上皮细胞层),细胞杂乱的紧密增生。轻度增生是指 2-4 层增生的腺细胞,旺炽性增生是指大于 4 层增生的腺细胞,可以形成实性的、筛状的或微乳头结构。
- 根据组织结构不同可分为以下几型:
- 实性型 UDH 表现细胞大小不等、形状各异,排列杂乱,可以出现导管周围裂隙样的空隙,肌上皮细胞层存在;
- 多孔型 UDH 表现为形成孔的腺腔不规则,腺腔大小和形状各异,经常裂隙样并出现在导管周围,和 ADH 及低级别 DCIS 中看到的圆形的、穿凿样的腺腔不同,不显示围绕腺腔的极向,排列杂乱、可以重叠;有些病例表现为梭形的腺细胞呈明显的流水样或旋涡状排列;
- 微乳头型的 UDH 表现为丛状乳头凸起,基底宽,越往上越细,微乳头之间的上皮也增生,有时微乳头型增生类似在男性乳腺发育和男性乳腺增生中看到的导管上皮增生。
- 细胞学特征:可以有合体细胞特征,单个细胞的边界不清;细胞是多克隆增生,而不是单克隆增生;细胞大小、形状及核方向多样,常见核沟及核内包涵体;偶尔可以看到核分裂;有时可以看到中心坏死,特别是在增生非常旺盛的区域;可以存在大汗腺化生或透明细胞化生,而且存在这些化生往往说明是良性改变而不是 ADH 或 DCIS。
- 间质成分:周围间质成分一般没有诸如导管周围纤维化或淋巴细胞浸润等改变。

免疫组织化学染色:
UDH 表现出混合细胞免疫表型,它是真正的多种细胞形态的多克隆性增生。ER 一般显示散在不均匀的分布,而 60%旺炽性 UDH 表现出 ER 的弥漫表达;高分子量角蛋白(CK5/6, CK14, or 34BE12)表现为弥漫性或马赛克样的表达模式,周围肌上皮细胞阳性;Ki67 增殖指数非常低,通常<5%。
分子标记:
1)基本没有发现 UDH 相关的整体的基因组改变; 2)在 50%的乳腺增生性疾病(UDH 和柱状细胞变)存在 PIK3CA 的点突变,而且增生性病变中 PIK3CA 的点突变经常伴发相邻癌的野生型的等位基因,有资料支持 PIK3CA 激活的点突变在上皮增生性病变中的作用比其作为肿瘤发生驱动器的作用更多;在大约 10%的病例出现杂合性丢失。 3)一个病人同时发生的 UDH 和癌的遗传表型常常不一致; 4)UDH 没有一致的分
鉴别诊断:
1. 不典型导管增生(ADH)
- ADH 是小的单克隆增生的细胞群,但不足以诊断为 DCIS;
- 典型的 ADH 为均匀一致的细胞填充部分导管管腔;
- 结构特征(如筛状结构或乳头形成等)没有 DCIS 中看到的完整;
- 相反的,UDH 由多种细胞表型组成,而不是单克隆性的;
- 对有疑问的病例高分子量 CK 的免疫组化是有帮助的:ADH 细胞是阴性的,但是因为 ADH 细胞并不充满导管管腔,因此在病变导管可以看到有一些阳性细胞存在,而 UDH 是有混合细胞表型组成,因此高分子量 CK 往往是散在片状分布的;如果病变很难区分是 ADH 还是 UDH,最好倾向诊断 UDH。 2. 低级别导管内癌(LGDCIS)
- 受累导管管腔扩张,并且充满单克隆的细胞;
- 很好地形成复杂的组织结构,包括筛状、实性、微乳头和乳头;
- 导管管腔一致受累;
- 典型的累及多个导管管腔;
- 均匀一致的细胞彼此分离、不重叠,细胞边界清晰;
- UDH 细胞常常没有如此一致的细胞表现和典型的组织结构。 **3. ** 实性乳头状癌 (SPC)
- 通常形成可触及的或影像上可见的肿块,而 UDH 大多数是偶然发现;
- 细胞充满多个局限的空间,空间比 UDH 累及的空间大得多;
- 受累区域可以看到纤维脉管轴心;
- 肌上皮细胞可以散在或缺如,如果存在肌上皮细胞应该分类为 DCIS,如果肌上皮细胞缺如同时又有浸润发生应该归类为浸润性癌;
- 当存在梭形细胞且呈旋涡状排列的时候可以类似 UDH;
- 高分子量 CK 阴性;
- 神经内分泌标记经常阳性(Syn 和 CgA)
预后:
对具有普通型导管增生的病人的长期随访结果发现这些病人以后有轻度发展为浸润性癌的危险性。
治疗:
UDH 是一种良性病变,一般不做进一步处理。
参考文献:
